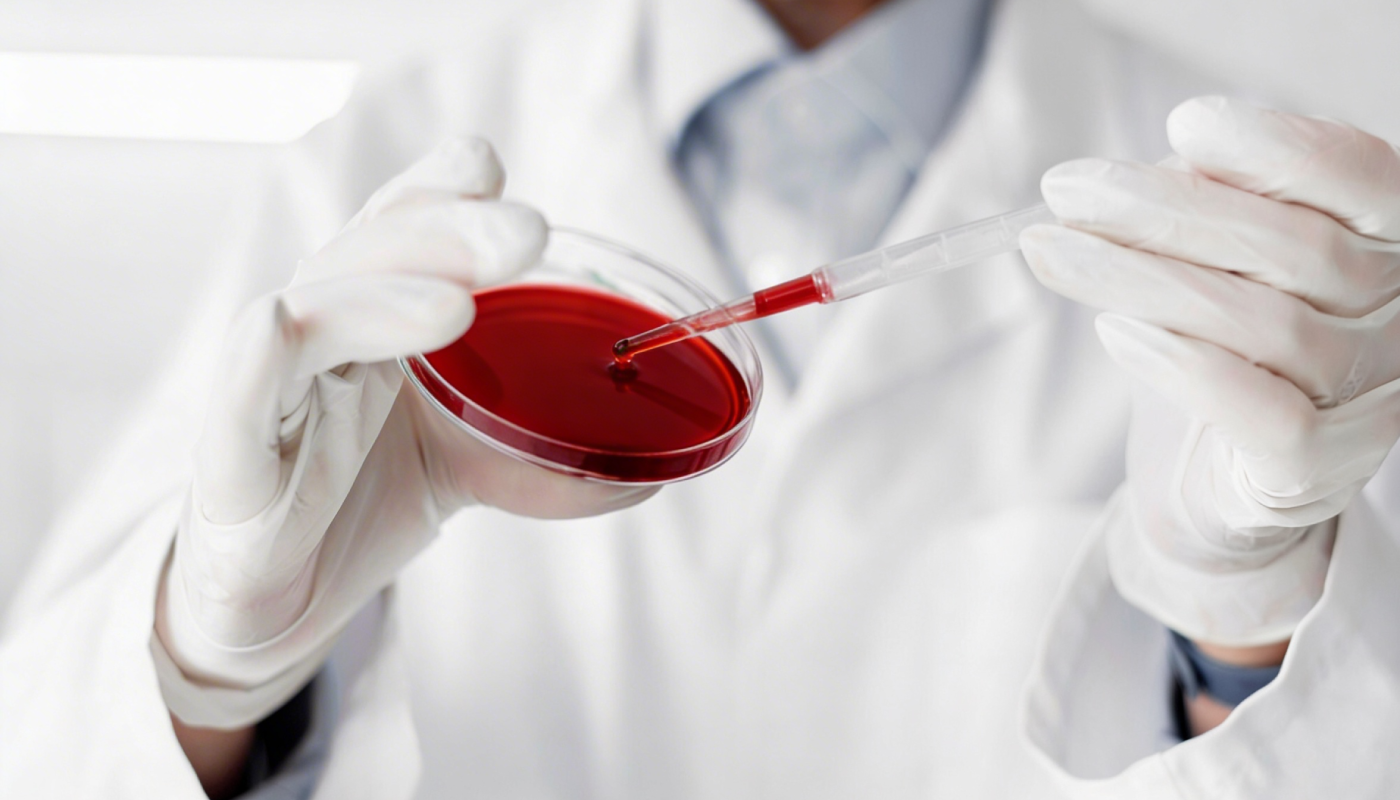
PRF설명01

100% 無항응고제
인위적인 화학 첨가물을 전혀 사용하지 않아 산성 성분으로 인한 시술 통증이 거의 없고, 자가 혈액의 자연적인 치유 반응을 극대화합니다.

14일간의 강력한 지속력
단기적으로 작용하는 기존 치료와 달리, 주입 후 조밀한 피브린 네트워크를 형성하여
최대 10~14일간 성장인자를 고농도로 지속 방출합니다.

2.5배 빠른 혈관화
활성화 과정을 통해 줄기세포와 내피세포의 작용을 강화하여,
일반 PRF 대비 혈관 생성 속도를 약 2.5배 가속화합니다.

물리적 활성화
화학적 활성화제가 아닌 특허받은 마이크로 튜블링(Microtubule)기술로
세포를 깨워 재생 에너지를 폭발시킵니다.
100% 無항응고제
인위적인 화학 첨가물을 전혀 사용하지 않아 산성 성분으로 인한 시술 통증이 거의 없고, 자가 혈액의 자연적인 치유 반응을 극대화합니다.

14일간의 강력한 지속력
단기적으로 작용하는 기존 치료와 달리, 주입 후 조밀한 피브린 네트워크를 형성하여 최대 10~14일간 성장인자를 고농도로 지속 방출합니다.

2.5배 빠른 혈관화
활성화 과정을 통해 줄기세포와 내피세포의 작용을 강화하여, 일반 PRF 대비 혈관 생성 속도를 약 2.5배 가속화합니다.

물리적 활성화
화학적 활성화제가 아닌 특허받은 마이크로 튜블링(Microtubule)기술로 세포를 깨워 재생 에너지를 폭발시킵니다.
세계 최초 활성 혈소판(위족) 전자현미경 사진 [연세대 전자현미경실 제공]
Activation
같은 혈액이라도
‘어떻게 활성화하느냐’에 따라
결과는 달라집니다.
항응고제나 화학 활성제를 사용하지 않고
혈액이 가진 자연 응고 과정을 그대로 활용합니다.
이 과정에서 형성되는 조밀한 섬유소(Fibrin) 네트워크는
혈액이 가진 자연 응고 과정을 그대로 활용합니다.
이 과정에서 형성되는 조밀한 섬유소(Fibrin) 네트워크는
성장인자를 한 번에 방출하지 않고
필요한 시점에, 필요한 만큼 지속적으로 전달합니다.
세계 최초 활성 혈소판(위족) 전자현미경 사진 [연세대 전자현미경실 제공]
Activation
같은 혈액이라도
‘어떻게 활성화하느냐’에 따라
결과는 달라집니다.
항응고제나 화학 활성제를 사용하지 않고
혈액이 가진 자연 응고 과정을 그대로 활용합니다.
이 과정에서 형성되는 조밀한 섬유소(Fibrin) 네트워크는
이 과정에서 형성되는 조밀한 섬유소(Fibrin) 네트워크는
성장인자를 한 번에 방출하지 않고
필요한 시점에, 필요한 만큼 지속적으로 전달합니다.
Technology
왜 활성 PRF인가?
활성화된 PRF는 PRF의 기존 특성을 더욱 향상시켜, 우수한 성능을 보입니다.
특히, 물리적 스트레스(Microtubule)활성화로 액상 상태를 유지해 극소 부위 정밀 주사가 가능합니다.
특히, 물리적 스트레스(Microtubule)활성화로 액상 상태를 유지해 극소 부위 정밀 주사가 가능합니다.
| 항목 | 2세대 일반 PRF | 3세대 엑셀바이오 PRF |
|---|---|---|
| 시기 | 2000년~ | 세계 최초 엑셀바이오 2024년~ |
| 제형 | 막(Membrane), 겔 | 액상형 및 주사 가능 |
| 형성 방식 | 원심분리 후 Clotting | 활성화 후 냉장에서 3시간 No-clotting |
| 활성화 방법 | 자연 응고(비활성), 화학적 활성화 방식 -> Cacl₂, 트롬빈 |
물리적인 스트레스 활성화 방식 -> Microtubule |
| 성장인자 방출 | 지속적이고 느림 | 즉각적이고 강하며 고농도로 10일 이상 지속적인 방출 |
| 치료 효과 | 서서히 상처 치유 유도 | 빠르고 강력한 항염 치료 및 재생 효과 |
Technology
왜 활성 PRF인가?
활성화된 PRF는 PRF의 기존 특성을 더욱 향상시켜,
우수한 성능을 보입니다.
특히, 물리적 스트레스(Microtubule)활성화로 액상 상태를
유지해 극소 부위 정밀 주사가 가능합니다.
우수한 성능을 보입니다.
특히, 물리적 스트레스(Microtubule)활성화로 액상 상태를
유지해 극소 부위 정밀 주사가 가능합니다.
| 항목 | 2세대 일반 PRF | 3세대 엑셀바이오 PRF |
|---|---|---|
| 시기 | 2000년~ | 세계 최초 엑셀바이오 2024년~ |
| 제형 | 막(Membrane), 겔 | 액상형 및 주사 가능 |
| 형성 방식 | 원심분리 후 Clotting | 활성화 후 냉장에서 3시간 No-clotting |
| 활성화 방법 | 자연 응고(비활성), 화학적 활성화 방식 -> Cacl₂, 트롬빈 |
물리적인 스트레스 활성화 방식 -> Microtubule |
| 성장인자 방출 | 지속적이고 느림 | 즉각적이고 강하며 고농도로 10일 이상 지속적인 방출 |
| 치료 효과 | 서서히 상처 치유 유도 | 빠르고 강력한 항염 치료 및 재생 효과 |
Scientific Evidence
14일간의 약속
단기적인 기존 치료와 달리, 주입 후
조밀한 섬유소(Fibrin) 네트워크를 형성하여
최대 10~14일간 성장인자를 지속적으로 방출합니다.
조밀한 섬유소(Fibrin) 네트워크를 형성하여
최대 10~14일간 성장인자를 지속적으로 방출합니다.
즉, 일시적인 개선이 아닌 혈관을 따라
전신 재생 환경 자체를 활성화하는 데 목적을 둡니다.
Scientific Evidence
14일간의 약속
단기적인 기존 치료와 달리, 주입 후
조밀한 섬유소(Fibrin) 네트워크를 형성하여
최대 10~14일간 성장인자를 지속적으로 방출합니다.
조밀한 섬유소(Fibrin) 네트워크를 형성하여
최대 10~14일간 성장인자를 지속적으로 방출합니다.
즉, 일시적인 개선이 아닌 혈관을 따라
전신 재생 환경 자체를 활성화하는 데 목적을 둡니다.
Comparison
재생 의학의 정점
14일간 지속되는 활성 PRF의 힘
활성 PRF는 인위적인 항응고제 없이 자가 혈액의 성분을 100% 보존합니다.
일반 PRP가 한 시간 내에 효능이 소멸되는 것과 달리, 활성 PRF는 조밀한 섬유소(Fibrin) 네트워크를 형성하여
최대 14일까지 고농도의 성장인자를 지속적으로 방출하며 난치성 질환의 근본적인 재생을 돕습니다.
일반 PRP가 한 시간 내에 효능이 소멸되는 것과 달리, 활성 PRF는 조밀한 섬유소(Fibrin) 네트워크를 형성하여
최대 14일까지 고농도의 성장인자를 지속적으로 방출하며 난치성 질환의 근본적인 재생을 돕습니다.
| 항목 | PRP | 활성 PRP 정맥 주사 | 활성 PRF 섬유소 치료 |
|---|---|---|---|
| 채혈량 | 10~30cc | 10~30cc | 10~30cc |
| PRP 추출량 | 1~3cc | 15cc | 15cc |
| 항응고제 | 필요 | 필요 | 필요 없음 |
| 활성화 방법 | 자연 응고(비활성), 화학적 활성화 방식 -> Cacl₂, 트롬빈 |
물리적인 스트레스 활성화 방식 -> Microtubule |
물리적인 스트레스 활성화 방식 -> Microtubule |
| 성장인자 유지 | 1시간 | 7일 이상 활성화 세포 치료 | 10~14일 지속적으로 재생 치료 |
| 성장인자 방출 | 자연 방출(느림) | 즉각 방출(빠르고 강력) | 즉각적이고 강함(고농도) |
| 통증 | 아주 심함(ph4.5 강한 산성) | 없음 | 없음 |
| 치료 효과 | 서서히 효과 발현 | 빠른 조직 재생, 항염 효과 우수 | 빠른 조직 재생, 항염 효과 우수 |
| 섬유소 | 파괴 | 파괴 | 보존 |
| 미토콘드리아 산화질소 | 미미 | 6배 정도 방출 | 6배 정도 방출 |
| 성장인자 활성화 | 미미 | 강력한 세포 활성화 | 강력한 세포 활성화 |
| 섬유소 네트워크 | 없음 | 없음 | 네트워크된 활성 혈소판, 백혈구 |
| 엑소좀 분비 | 없음 | 있음 | 있음 |
Comparison
재생 의학의 정점
14일간 지속되는 활성 PRF의 힘
활성 PRF는 인위적인 항응고제 없이
자가 혈액의 성분을 100% 보존합니다.
일반 PRP가 한 시간 내에 효능이 소멸되는 것과 달리,
활성 PRF는 조밀한 섬유소(Fibrin) 네트워크를 형성하여
최대 14일까지 고농도의 성장인자를 지속적으로 방출하며
난치성 질환의 근본적인 재생을 돕습니다.
자가 혈액의 성분을 100% 보존합니다.
일반 PRP가 한 시간 내에 효능이 소멸되는 것과 달리,
활성 PRF는 조밀한 섬유소(Fibrin) 네트워크를 형성하여
최대 14일까지 고농도의 성장인자를 지속적으로 방출하며
난치성 질환의 근본적인 재생을 돕습니다.
| 항목 | PRP | 활성 PRP 정맥 주사 | 활성 PRF 섬유소 치료 |
|---|---|---|---|
| 채혈량 | 10~30cc | 10~30cc | 10~30cc |
| PRP 추출량 | 1~3cc | 15cc | 15cc |
| 항응고제 | 필요 | 필요 | 필요 없음 |
| 활성화 방법 | 자연 응고(비활성), 화학적 활성화 방식 -> Cacl₂, 트롬빈 |
물리적인 스트레스 활성화 방식 -> Microtubule |
물리적인 스트레스 활성화 방식 -> Microtubule |
| 성장인자 유지 | 1시간 | 7일 이상 활성화 세포 치료 | 10~14일 지속적으로 재생 치료 |
| 성장인자 방출 | 자연 방출(느림) | 즉각 방출(빠르고 강력) | 즉각적이고 강함(고농도) |
| 통증 | 아주 심함(ph4.5 강한 산성) | 없음 | 없음 |
| 치료 효과 | 서서히 효과 발현 | 빠른 조직 재생, 항염 효과 우수 | 빠른 조직 재생, 항염 효과 우수 |
| 섬유소 | 파괴 | 파괴 | 보존 |
| 미토콘드리아 산화질소 | 미미 | 6배 정도 방출 | 6배 정도 방출 |
| 성장인자 활성화 | 미미 | 강력한 세포 활성화 | 강력한 세포 활성화 |
| 섬유소 네트워크 | 없음 | 없음 | 네트워크된 활성 혈소판, 백혈구 |
| 엑소좀 분비 | 없음 | 있음 | 있음 |
이런 분들께 권해드립니다
난치성 피부 질환 및 탈모
아토피, 건선 등 만선 피부 질환의 확기전 개선 및
휴지기 모낭을 성장기로 전환하여 모발 재생 유도
턱관절 및 퇴행성 관절염
조밀한 피브린 네트워크를 통한 손상된 연골 및
조직 재건과 만성적인 통증의 근본적인 완화
화상 및 당뇨성 족부 궤양
일반적인 치료로 회복이 더딘 심각한 조직 손 분위의
강력한 혈관 신생 및 세포 재생 촉진
특수 자가 혈청 안약
심한 안구건조증, 황반변성 개선을 위한 항응고제 ZERO
고농축 활성 혈구 세포 기반의 맞춤형 안약
“이런 분들께 권해드립니다”
난치성 피부 질환 및 탈모
아토피, 건선 등 만선 피부 질환의 확기전 개선 및
휴지기 모낭을 성장기로 전환하여 모발 재생 유도
턱관절 및 퇴행성 관절염
조밀한 피브린 네트워크를 통한 손상된 연골 및
조직 재건과 만성적인 통증의 근본적인 완화
화상 및 당뇨성 족부 궤양
일반적인 치료로 회복이 더딘 심각한 조직 손 분위의
강력한 혈관 신생 및 세포 재생 촉진
특수 자가 혈청 안약
심한 안구건조증, 황반변성 개선을 위한 항응고제 ZERO
고농축 활성 혈구 세포 기반의 맞춤형 안약
Clinical Results
결과로 말하는 임상사례
난치성 질환의 해답, 엑셀바이오가 실제 사례로 증명합니다.
병력이 오래되지 않은 난치성 아토피, 건선, 가려움증 같은 피부 질환은
2주 간격으로 2~3회 활성 섬유소를 피하에 주사하면 완치와 같은 빠른 치료
효과를 볼 수 있습니다.


탈모 치료의 경우 30cc 채혈하여 약 5cc의 조혈모 미토셀 섬유소 주사를 만들어
Deep dermis에 가까운 피하지방층에 부위당 0.5~1cc 주사와 3주 간격으로
치료 PRF(microneedling + Actcellregen)합니다.
활성 PRF 치료를 시행하면서 Full Debridement First and second Twice Topical: 99.8% crocodile Oil+ Fucidine Powder covered by Duoderm Ultrathin.


활성 PRF 시행하였는데, dexa 치료의 피부 병변 호전보다
활성 PRF 치료가 확연한 개선속도가 있는 효과가 있습니다.
Clinical Results
결과로 말하는 임상사례
“난치성 질환의 해답,
엑셀바이오가 실제 사례로 증명합니다.”
엑셀바이오가 실제 사례로 증명합니다.”

병력이 오래되지 않은 난치성 아토피, 건선, 가려움증 같은 피부 질환은 2주 간격으로 2~3회 활성 섬유소를 피하에 주사하면 완치와 같은 빠른 치료 효과를 볼 수 있습니다.

탈모 치료의 경우 30cc 채혈하여 약 5cc의 조혈모 미토셀 섬유소 주사를 만들어 Deep dermis에 가까운 피하지방층에 부위당 0.5~1cc 주사와 3주 간격으로 치료 PRF(microneedling + Actcellregen)합니다.
활성 PRF 치료를 시행하면서 Full Debridement First and second Twice Topical: 99.8% crocodile Oil+ Fucidine Powder covered by Duoderm Ultrathin.


활성 PRF 시행하였는데, dexa 치료의 피부 병변 호전보다
활성 PRF 치료가 확연한 개선속도가 있는 효과가 있습니다.
Technical Infrastructure
독보적인 기술 인프라

“글로벌 특허가 입증한 ACT PRO AUTO 시스템”
한국과 미국에서 동시에 특허를 획득한 독자적인 ‘마이크로 튜블링’ 기술은
오직 ACT PRO AUTO 전용 시스템을 통해서만 구현되는 핵심 활성화 공법입니다.
기성 키트의 한계를 넘어 정밀한 물리적 자극으로 고농도 성장인자와
엑소좀의 즉각적인 방출을 유도하며, 자동화된 정밀 제어 시스템을 통해
시술 환경에 관계없이 항상 균일하고 압도적인 전신 재생 효과를 보장합니다.
Technical Infrastructure
독보적인 기술 인프라

“글로벌 특허가 입증한
ACT PRO AUTO 시스템”
ACT PRO AUTO 시스템”
한국과 미국에서 동시에 특허를 획득한 독자적인 ‘마이크로 튜블링’ 기술은 오직 ACT PRO AUTO 전용 시스템을 통해서만 구현되는 핵심 활성화 공법입니다.
기성 키트의 한계를 넘어 정밀한 물리적 자극으로 고농도 성장인자와 엑소좀의 즉각적인 방출을 유도하며, 자동화된 정밀 제어 시스템을 통해 시술 환경에 관계없이 항상 균일하고 압도적인 전신 재생 효과를 보장합니다.
“자가 혈액의 힘을 극대화한 생체 친화적 안전 설계”
본인의 혈액을 그대로 활용하는 100% 자가 혈액 재생 요법으로
외부 물질 투여로 인한 거부 반응이나 부작용 걱정 없는 근본적인 안전성을 확보했습니다.
물리적으로 활성화된 혈구 세포는 주입 즉시 강력한 항염 사이토카인과
엑소좀을 방출하여 신체 스스로 염증과 통증을 능동적으로 제어하도록 유도하며,
세포 자체의 통증 완화 메커니즘을 통해 별도의 마취 없이도 가장 편안한 상태에서
혁신적인 항노화 케어를 경험하실 수 있습니다.


“자가 혈액의 힘을 극대화한
생체 친화적 안전 설계”
생체 친화적 안전 설계”


